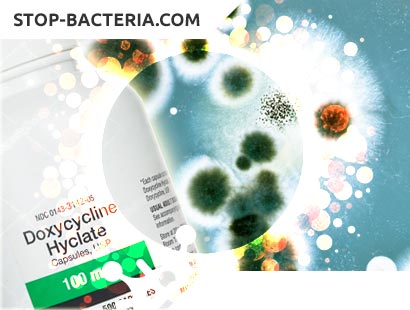
doxycycline online usa

Le corps humain est une machine complexe composée de différentes cellules, tissus et os. Notre corps est sujet aux différents types d'infections au cours de la vie. Certaines maladies sont facilement éradiquées de notre machine par son système immunitaire. Mais pour d'autres infections graves et critiques, nous avons besoin d'une aide supplémentaire avec des médicaments pour lutter contre ces germes et garder votre corps en bonne santé et en forme. Il existe différents types d'antibiotiques disponibles sur le marché qui aident à lutter contre les maladies qui nous dérangent. Une de ces merveilles du monde médicinal moderne est un type d'antibiotique tétracycline appelé Doxycycline. Essayons de savoir ce qu'est ce médicament?
Qu'est-ce que Doxycycline?
Outre un antibiotique, ceci est utile dans divers types d'infections de bactéries telles que l'acné, les infections urinaires, les germes dans les intestins, les infections oculaires, les maladies des gencives, la gonorrhée et la chlamydia. C'est aussi un traitement efficace contre les imperfections, les bosses et la rosacée (lésions). Une partie de sa variété est également un traitement des germes causés par les acariens, les tiques ou les poux et utile dans la prévention du paludisme mortel.
Quels sont les noms de marque de Doxycycline?
Il existe de nombreux noms de marque disponibles pour ce médicament. Certaines des marques célèbres sont Atridox, Acitclate Cap, Doxteric, Doxy, Oracea, Monodox, Vibramycine.
Pourquoi les médecins prescrivent-ils ce médicament aux patients?
Si vous avez l'un de ces problèmes mentionnés ci-dessous, vous recevrez ce médicament par votre médecin:
- Urétrite non gonococcique
- Fièvre pourprée
- La maladie de Typhus
- Problèmes liés au Chancroid
- Infection à la brucellose
- Choléra
- Anthrax
- Maladie syphilis
- Majorité de l'acné
- Maladie parodontale
- Différents types d'infections
- Hémophilus influenza (voies respiratoires)
- Streptococcus pneumonia
Quelles sont les variétés de Doxycycline disponibles sur le marché?
- Différentes forces de capsules telles que 50 mg, 75 mg, 100 mg et 150 mg
- Capsule de 40 mg (avec libération retardée)
- Comprimés de différentes forces 20 mg, 50 mg, 75 mg, 100 mg et 150 mg
- Comprimés en 55mg, 60mg, 75mg, 80mg, 100mg, 120mg et 200mg (avec libération retardée)
- Sirop de 50 mg ou 5 ml
- Suspension orale de 25 mg ou 5 ml
- Poudres injectables de 100 mg et 200 mg
- Liquide pour les rejets parodontaux prolongés de 10%
Comment ce médicament doit-il être conservé?
On peut conserver des capsules, des comprimés et des sirops à une température moyenne d'environ 15 à 30 degrés Celsius dans un récipient hermétique. La poudre d'injection doit être protégée de la lumière du soleil et inférieure à la température de 25 Celsius. Doxycycline est également disponible sous forme de gel pour les infections sous-gingivales (connu sous le nom Atridox) peut être conservé à une température froide de 2 Celsius à 8 Celsius.
Choses à se rappeler avant de prendre ce médicament
Vous ne devez pas prendre ce médicament si vous êtes hypersensibles à la doxycycline ou à d'autres agents anti-infectieux, par exemple la déméclocycline, la minocycline, les antibiotiques ou la tigécycline. Pour vous assurer que la doxycycline vous convient, dites à votre spécialiste si vous avez déjà:
- Une infection du foie
- Une infection rénale
- asthme ou hypersensibilité aux sulfites
- le poids augmenté à l'intérieur de votre crâne; ou
- si vous prenez en plus de l'isotrétinoïne, un médicament antiépileptique ou un anticoagulant, par exemple, la warfarine (Coumadin).
Précautions avant de commencer ce médicament
Si vous utilisez la doxycycline pour traiter la gonorrhée, votre spécialiste peut vous tester pour vous assurer que vous n'avez pas la syphilis, une autre maladie sexuellement transmissible.
Prendre cette prescription pendant la grossesse peut influencer le développement des dents et des os chez l'enfant à naître. La prise de doxycycline dans la deuxième moitié de la grossesse peut entraîner une modification de la couleur de la dent d'origine de l'enfant. Dites à votre spécialiste si vous êtes enceinte ou au hasard que vous finissez enceinte pendant l'utilisation de ce produit pharmaceutique.
Doxycycline peut influencer les pilules contraceptives pour devenir moins convaincant. Obtenez des informations sur l'utilisation d'un médicament anti-conception non hormonal (comme un préservatif, l'estomac avec un spermicide) pour éviter la grossesse. La doxycycline peut influencer l'avancement des os et des dents chez un bébé par l'alimentation des seins. Essayez de ne pas nourrir votre bébé avec votre lait pendant que vous prenez ce médicament.
Les jeunes ne devraient pas utiliser ce médicament. Il peut causer une coloration jaune ou sombre permanente des dents chez les enfants de moins de huit ans. Les jeunes devraient ingérer de la doxycycline seulement dans des situations dangereuses, par exemple, Bacillus anthracis ou la fièvre des montagnes Rocheuses. L'avantage de traiter une condition naturelle peut dépasser tous les dangers pour l'amélioration des dents de l'enfant.

Comment devriez-vous prendre ce médicament?
Prenez la doxycycline précisément comme approuvé par votre spécialiste. Essayez de ne pas prendre ce médicament en plus grandes ou plus petites sommes ou pour plus longtemps que suggéré. On devrait prendre la doxycycline avec un verre d'eau. Buvez beaucoup de liquides pendant que vous prenez ce médicament. La plupart des marques de doxycycline peuvent être combinées avec vos repas ou avec du lait si le médicament affecte votre estomac. Diverses marques de doxycycline peuvent avoir des instructions pour les avoir avec ou sans repas. Prenez Oracea devrait être consommé, pas moins de 1 heure avant ou 2 heures après le souper.
Vous pouvez ouvrir une capsule ou séparer un comprimé homogène et saupoudrer la solution dans une cuillerée de n'importe quelle purée de fruit pour faciliter l'engloutissement. Avaler immédiatement sans mordre. Essayez de ne pas stocker le mélange à des fins suivantes. Buvez au moins huit onces d'eau fraîche immédiatement. Essayez de ne pas casser, ou ouvrez un type de contenant ou de tablette retardé. Juste avaler la pilule. Vous devrez peut-être séparer un comprimé de doxycycline pour obtenir le bon dosage tel que prescrit par votre médecin.
Mesurer la forme fluide du médicament avec la seringue doseuse, ou avec une cuillère à dose régulière ou un contenant pharmaceutique. Au cas où vous prenez de la doxycycline pour anticiper la fièvre de la jungle: Commencez à prendre la drogue 1 ou 2 jours avant d'entrer dans un territoire où cette maladie est fréquente. Continuez à prendre les médicaments pendant votre séjour et pendant au moins un mois après votre départ de la région. Utilisez une robe défensive, des anti-agents crawly crawly, et des moustiquaires autour de votre lit pour les moustiques qui pourraient causer le paludisme.
Utilisez ce médicament pour la période complète approuvée. Votre infection peut augmenter avant que la maladie soit évidente de votre corps. Sauter des doses peut également créer votre danger de germes supplémentaires. Doxycycline ne considérera pas une maladie virale, par exemple, les virus du rhume de saison. Au cas où vous auriez besoin d'une intervention chirurgicale, dites au spécialiste tôt que vous utilisez de la doxycycline. Jeter les médicaments expirés après avoir vérifié l'étiquette car elle fournit des dommages à vos reins à long terme.
Quels sont les effets secondaires de ce médicament?
Obtenir une assistance médicale sur les indications d'une réponse hypersensible à la doxycycline. Tels que l'urticaire, respiration gênante, gonflement du visage ou de la gorge ou une réaction cutanée sévère (fièvre, mal de gorge, consommation dans les yeux, agonie de la peau, éruption cutanée qui se propage et provoque le froncement et l'épluchage).
Cherchez un traitement médical au cas où vous auriez une véritable réponse médicamenteuse qui pourrait influencer de nombreuses parties de votre corps. Les indications peuvent inclure: une éruption cutanée, de la fièvre, des organes enflés, des effets secondaires de type grippal, des douleurs musculaires, de la faiblesse, des blessures ou un jaunissement de la peau ou des yeux. Cette réponse peut survenir une demi-mois après avoir commencé à utiliser la doxycycline.
Appelez votre spécialiste sans délai si vous avez:
- des maux d'estomac extrêmes, des intestins lâches qui contiennent de l'eau ou du sang;
- Irritation de la gorge, dérangement
- mal de poitrine, battements cardiaques imprévisibles, essoufflement;
- vous ne pouvez pas faire pipi du tout
- faible numération des globules blancs - fièvre, gonflement des glandes, douleurs corporelles, symptômes de la grippe, blessure ou saignement;
- le poids expansé à l'intérieur du crâne - douleurs cérébrales sévères, bourdonnements dans les oreilles, problèmes de vision, yeux douloureux
- indications de problèmes de foie ou de pancréas - perte de désir, maux de ventre (qui peuvent se propager dans le dos),
- fatigue, problèmes de vomissements, rythme cardiaque rapide, pipi terne, jaunisse (jaunissement de la peau ou des yeux).
Les symptômes primaires de la doxycycline peuvent inclure:
- Nausées ou vomissements,
- diarrhée légère,
- le relâchement moelleux des intestins;
- éruption cutanée ou picotement; ou
- picotements vaginaux ou libération de liquide.
Espérons que cette information sur la drogue utile et crédible (Doxycycline) aiderait les lecteurs d'une manière significative. Il est essentiel de connaître les informations détaillées sur ce médicament et son fonctionnement. Pour tout effet indésirable de la drogue, consultez toujours votre médecin. Prendre soin de vous et de vos proches et vivre une vie saine est une chose que tout être humain devrait faire. Comme il est dit, "la santé est la richesse".
Dangers de surutilisation d'antibiotiques
Il y a une utilisation croissante des antibiotiques que jamais auparavant. Les gens utilisent des antibiotiques sans aucune transcription médicale croyant qu'il peut être efficace pour guérir leurs maladies dans les plus brefs délais. Mais, la plupart des chercheurs et des études ont trouvé cela très dangereux.
De nombreuses études et statistiques ont montré clairement que la surutilisation des antibiotiques peut entraîner de graves conséquences pour la santé. Ils insistent également sur la nécessité d'arrêter de l'utiliser quand ce n'est pas nécessaire. En outre, ils exhortent les gens à consulter leurs médecins, car il est indispensable de le faire, car ils savent clairement comment les antibiotiques peuvent nuire à l'individu plutôt que de guérir et de les aider à surmonter leurs maladies.
Antibiotiques: à quoi servent-ils?
Les antibiotiques sont utilisés pour les infections, mais seulement dans certains cas. Tous les individus ne peuvent pas le prendre sans transcriptions médicales. Aussi appelés agents anti-infection doivent être parmi les solutions les plus couramment endossées dans la prescription actuelle. Les agents anti-infectieux guérissent la maladie en abattant ou en endommageant les organismes microscopiques.
Prenant un exemple, nous pouvons mentionner la pénicilline, qui se trouve incidemment à partir d'une culture de forme. Grâce au développement médical, plus d'une centaine d'agents antibiotiques uniques sont pleinement accessibles aujourd'hui. Les antibiotiques sont également utilisés pour soigner les contaminations mineures et dangereuses.
Les dangers de l'abus des antibiotiques
Les antibiotiques ont été jugés moins viables pour certaines sortes de contaminations bactériennes. À ce stade, lorsqu'un antibiotique n'affecte pas certaines souches d'organismes microscopiques, on parle de micro-organismes anti-infectieux. Au moment où les organismes microscopiques survivent au traitement anti-infectieux, ils peuvent dupliquer et échanger de manière significative ces propriétés sans danger pour les médicaments contre divers microbes.
La protection contre les antibiotiques est un modèle préoccupant qui est influencé par l'abus et l'abus d'agents anti-infectieux. La nécessité d'une protection urgente est favorisée par une utilisation abusive des antibiotiques, en particulier lorsqu'ils sont approuvés pour des maladies pour lesquelles un traitement antimicrobien ne convient pas. En outre, les agents antibiotiques doivent être utilisés pour traiter uniquement les maladies bactériennes, et non les contaminations causées par les infections.
En Angleterre par exemple, 25 000 personnes meurent d'infections causées par des bactéries résistantes.
Résistance aux antibiotiques
La résistance aux antibiotiques doit être l'une des plus grandes préoccupations des médecins aujourd'hui. Il a mis un grand danger dans la sécurité alimentaire et l'avancement de la médecine. Il peut influencer n'importe quel âge et n'importe quel dans le monde entier.
La résistance aux antibiotiques doit se produire normalement, et parfois les gens avec leur surutilisation peuvent rendre le processus de plus en plus dangereux et rapide.
La surutilisation de l'antibiotique peut créer un corps qui ne répond pas qui ne peut pas accepter le traitement. En d'autres termes, si l'individu utilise une grande quantité d'antibiotiques sur une longue période, sans la permission de son médecin, ou sans prescription médicale, il ne peut plus accepter le traitement. En conséquence, bien que les médecins puissent prescrire pour lui le bon antibiotique à utiliser dans une maladie grave, son corps deviendra résistant aux antibiotiques.
La surprescription d'anti-toxines est liée à un risque accru d'impacts hostiles, à une participation plus incessante et à un besoin médical accru de conditions d'auto-restriction. La surprescription d'antibiotiques est un problème spécifique dans les soins essentiels, où les infections provoquent généralement des contaminations.
Nous pouvons dire que 90% de chaque remède antibiotique unique est délivré par des professionnels généraux, et les contaminations des voies respiratoires sont le but principal derrière la recommandation.
Quelques mesures pour arrêter la résistance aux antibiotiques
Les programmes de gestion des antimicrobiens (PSA), par exemple, ont établi de nombreuses mesures et collaborations pour vraiment minimiser et aider à améliorer la thérapie antimicrobienne et réduire les coûts du traitement, tout en améliorant la sécurité clinique et les résultats. En outre, ces mesures ont tendance à réduire nettement et à stabiliser la résistance des antibiotiques.
D'autres mesures doivent être liées à ne pas permettre l'accessibilité des antibiotiques sur le marché pour un usage personnel. Une personne doit consulter son médecin avant d'utiliser tout type d'antibiotiques.
Utilisation prudente des antibiotiques
Les antibiotiques doivent être les plus dangereux pour l'individu, l'utilisation prudente peut conduire à de bons résultats. De nombreuses études ont montré qu'un grand nombre d'individus ne sont pas conscients de l'utilisation des antibiotiques, et qu'ils peuvent conduire dans certains cas à la mort.
L'individu ne doit prendre des antibiotiques que selon les recommandations du spécialiste. L'individu doit prendre la dose quotidienne approuvée et être certain de finir tout le cours de son traitement. En outre, c'est indépendamment du fait qu'il se sente mieux ou pas avant de finir les médicaments. La nécessité de demander au médecin combien utiliser et ne négliger aucune des mesures proscrites.
Doit utiliser seulement celui prescrit ne pas utiliser une dose de quelqu'un ou d'une maladie passée. En outre, ne pas demander, ou forcer le médecin à donner un remède anti-infectieux. Doit utiliser et adopter l'approche la plus idéale pour traiter vos manifestations.






